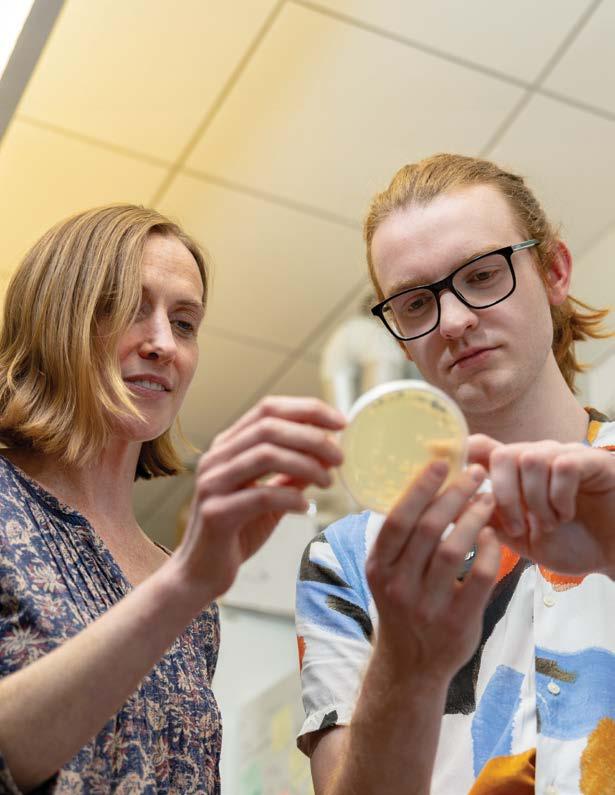

Ready
the world SUMMER 2024
for Launch Creating leaders who will transform

Trinity University’s recent graduates have a 98% positive outcomes rate.
This means that 98% of the graduates in the Class of 2023 had jobs or were accepted to graduate school within six months of graduation.
How? Because when they’re ready to launch, Trinity degrees are putting our students in a position to reach success on whatever terms they’re aiming for. Tigers are curious, creative leaders, ready to transform themselves and the world around them.
Flip through these pages to see how our Tigers are set up for success.
The Trinity Perspective magazine offers a glimpse into the many ways Trinity University prepares students to lead lives of meaning and purpose. Trinity is known for its stimulating, resourceful, and collaborative environment, filled with students who want an education that instills confidence, inspires curiosity, and ignites change. Flip through these pages to see for yourself!
GET CONNECTED
Follow Trinity University on social media and join the conversation.
Have a question for a current student?
Email your questions to students at AskATiger@trinity.edu
Have a question for an admissions officer, faculty member, or other staff member?
Email us at admissions@trinity.edu and we’ll get it answered.
THE OFFICE OF ADMISSIONS
Trinity University
One Trinity Place San Antonio, Texas 78212 admissions@trinity.edu www.trinity.edu/admissions 1-800-TRINITY



Trinity University is a private, residential, co-educational institution in the heart of vibrant, intercultural San Antonio. Trinity offers its 2,500 undergraduate students an education rooted in the liberal arts and sciences that prioritizes hands-on learning, emphasizes undergraduate research, and develops strong leadership skills.
3


A Night on the Town, for Credit
Hands-on music course sends students to symphony concerts in downtown San Antonio
By Kennice Leisk ’22 and Emma Utzinger ’24
Orchestral music is almost omnipresent in our entertainment landscape—it forms the basis of movie soundtracks, video game soundtracks, and musical theater, and it even inspires iconic pop songs.
But when was the last time you had the chance to sit down and solely focus on the orchestra, the musicians, and the instruments?
For Trinity University students, the “Nights at the Symphony” course has got them covered.
Taught by music professor Carl Leafstedt, MUSC 1344, or “Nights at the Symphony,” gives Trinity students class credit for attending symphony
concerts in downtown San Antonio.
“Good concerts. New music. Nights out on the town—for credit. What’s not to like?” Professor Leafstedt says.
Though it’s a music class, students don’t need to have musical experience to take part in “Nights at the Symphony.” Students of all backgrounds are encouraged to join the class, and Professor Leafstedt ensures that the course feels engaging for all students, no matter their level of musical experience.
“Dr. Leafstedt creates a wonderfully open and welcoming atmosphere for students who might not have a history in music or attending orchestra
concerts while still keeping it engaging for the musicians in the room,” says Samantha Sandal ’24, a recent alumna who was a percussionist in Trinity’s Symphonic Wind Ensemble, Symphony Orchestra, and Percussion Ensemble.
Throughout the semester, students get the chance to watch six to seven orchestra concerts around San Antonio. Most concert tickets are offered at a deeply reduced price, and some concerts are even free. To help prepare them for the concerts, Professor Leafstedt familiarizes his students with the music, guest artists, and conductors for the upcoming
Samantha Sandal ’24 (left) and Madison Reich ’24 attend a San Antonio Philharmonic performance for their “Nights at the Symphony” course.
4
It has been fun getting to explore what constitutes an orchestra.
show. After attending the concerts, the students write concert reviews, which constitute the majority of their grades in the course.
“I am no stranger to music, but being able to first learn about the history of the pieces and then listen for particular moments of interest during the performance just makes the entire symphony experience more exciting as you find yourself catching things that you would never have noticed before,” Sandal says.
Through lectures and readings in arts management, the course also touches on the business of running a modern orchestra. “I served on the board of the San Antonio Symphony, which exposed me to the business side of running a large nonprofit organization,” Professor Leafstedt says. “I integrate discussions about nonprofit management into the course, giving students a different view of what they’re seeing.”
The San Antonio Symphony went bankrupt in 2022, and within months the San Antonio Philharmonic was up and running as its successor organization. “We are getting to watch as they rebuild a cultural centerpiece of the city,” Sandal says. “It has been fun getting to explore what constitutes an orchestra, from the instruments to the behind-the-scenes directorial work and how symphonies are formed and operated.”
Ultimately, Professor Leafstedt hopes this course will remind his students that classical music is for everyone, not just musicians or conductors. “Everyone in the course will take something different away from the experience,” he says. “My goal is to create lifelong learners who don’t find the concert hall intimidating.”

Learning Beyond the Classroom
Music education student interns with San Antonio Philharmonic
By Gabriela Salgado ’25
In Summer 2023, Professor Leafstedt mentored music education major Jake Cipolla ’26 as part of Trinity’s Arts, Letters, and Enterprise (ALE) program. For his ALE internship, Jake worked with the burgeoning San Antonio Philharmonic.
As an intern, Jake engaged in the behind-the-scenes work of a nonprofit organization: helping with grant applications, working with donors, and creating campaigns and designs. He also gained more experience with Microsoft Excel and learned how to use Little Green Light, a software used for entering grant and gift information for organizations.
Jake had a flexible schedule and worked mostly from his dorm, where he lived the entire summer for no cost as part of the ALE program. Working remotely helped him develop time management skills and master virtual communication.
After the Philharmonic’s season ended, Jake analyzed data from the season’s ticket sales to find information about ticket revenue and the buyers’ demographics.
Though most of his work was data-driven, Jake says, “This internship gave me the chance to make more connections within the music community of San Antonio, expanding my network.”
5
Jake Cipolla ’26 (center) and his coworkers attend the last concert of the San Antonio Philharmonic’s season.

Trinity student makes discoveries at the intersection of AI, biology, and computer science
By Jeremy Gerlach
On a weekly basis, Cole McGuire ’25 stands at an intersection of two different worlds.
A computer science major who came to Trinity University with a passion for biology, he’s using this unusual combination of interests to conduct interdisciplinary research that could have huge implications for how machines (namely, computer algorithms) can solve some of humanity’s biggest biological mysteries.
“I have a passion for research in two things that seem in some ways almost polar opposites: the natural world and the artificial one. Trying to get those to interact in a way that can be beneficial to us has been just fascinating,” Cole says.
At Trinity, Cole works alongside an interdisciplinary duo of computer science professor Matthew Hibbs and biology professor Bethany Strunk. Now in a third year of research, the team’s project, “A Deep-Learning Approach to Gene Function Prediction,” is building on a tantalizing way to use AI to speed up the human understanding of genes, which in turn has potentially crucial applications for fields such as cancer research.
There’s a name for this crossover field: bioinformatics. “I like to think of it as trying to solve biological problems using the tools and abilities of computer science,” Professor Hibbs explains.
6
Cole was seemingly destined to excel in this bioinformatics field as a student at Trinity, where the liberal arts put students seeking hands-on opportunities that bridge disciplines in a position to thrive. Alongside his computer science major, he’s a biology minor (just a few classes short of a major) and a philosophy minor to boot.
tackle,” Professor Hibbs says. “With a student like Cole, you get to ask a whole different set of questions.”
Cole says he is guardedly excited about AI’s potential for their field. His current research is giving him the chance to get hands-on experience with a tool that’s going to be a huge part of whatever career field in computer science he chooses to pursue.
I have a passion for research in two things that seem in some ways almost polar opposites: the natural world
and the artificial one.
“With computers, we’re able to achieve and do some things that feel like magic,” Cole says of his passion for computer science. “Whereas with biology, it is fascinating to take a glimpse into these extremely complex systems that are all working in harmony. Uncovering a little bit of these threads that wind in specific places can improve our quality of life so much.”
After Cole decided to enroll at Trinity, he took a First-Year Experience (an interdisciplinary class for new Tigers) in science fiction, where he met many of his future classmates in biology, computer science, and other STEM fields. And as Cole moved into the computer science field, he ended up being a godsend for Professor Hibbs, who needed a student with an interdisciplinary perspective.
“When you get that student who understands both worlds, there are different problems that they can
“AI has not gotten to the point where it really scares me in terms of its potential, but I do think you’re starting to see it dipping its toes into every area of our lives,” Cole says. “Being someone who’s working on a very specialized use of AI in a non-computer-science field shows me the wide array of potential it has, but it also shows me some of the limitations, and it shows me the places we still have to go.”


Hear from Cole, Professor Hibbs, and Professor Strunk
top After working together for three years, computer science professor Matthew Hibbs and Cole McGuire ’25 have developed a strong collaborative partnership. bottom Cole has high hopes for the future of AI in his research field.
7
about their research.


Leading by Example
Trinity

student leader lands an internship with a Fortune 500 company
By Kennice Leisk ’22 and Layal Khalil ’27
As a track and field student-athlete, a member of Trinity University’s DEI committee, and the judicial chair of the Student Government Association, Pierce Jackson ’25 has risen as a leader on campus. And, though he’s just a junior, Pierce is already applying his Trinity experiences to be a leader in his career field.
Initially, Pierce came to Trinity determined that computer science and math weren’t for him. But after getting advice from a friend and fellow student-athlete, Pierce decided to give a business analytics and technology major a chance. He soon realized
his natural knack for computers and analytical thinking, and now he’s lined up an investment banking operations internship at Goldman Sachs for Summer 2024.
“I am beyond excited to be able to work for such a company as Goldman Sachs. This summer, I hope to learn the intricacies of investment banking and see the way financial transactions happen outside of the classroom. I am bound to meet some incredible people while I am there, and I am sure that I will get to make lifelong connections with those around me,” Pierce says. “To have a name like Goldman Sachs on
my resume will set me up for amazing opportunities in my professional life that I will take advantage of to help me progress to my future goal of being the CEO of a Fortune 500 company.”
Through his various leadership positions on campus, Pierce has realized he is a lead-by-example person, a skill that will benefit him in his ambitions to be a CEO.
“I don’t want to be the leader who intimidates people but one that makes them feel welcome and at home. Still, I also make sure that, while being friendly, I am also holding them and myself to a standard of excellence every
His time as an officer for Trinity’s Student Government Association and as a student-athlete has taught Pierce Jackson ’25 important lessons about leadership.
8
Trinity is an amazing place that has someone for everyone, and finding that ‘someone’ to be a rock is so important.

day so that they can also achieve the goals that they have set for themselves,” Pierce says. “This mindset has changed me personally as I make sure to be the best I can every day in every aspect so that I can continue to be a great leader to others both on and off the field.”
Taking on multiple responsibilities can be challenging, but Pierce finds balance through music, specifically playing the piano. “The piano is a safe space for me to get away from school, sports, and work and let out all my emotions. This time I have with my thoughts is what helps to bring me peace throughout the day,” Pierce says.
Behind every great leader is a great support system, and Pierce has found that at Trinity. “My roommate and my other close friends on the track team have picked me up at my lowest points and made sure that I keep working hard and sticking to my goals,” Pierce says. “Trinity is an amazing place that has someone for everyone, and finding that ‘someone’ to be a rock is so important.”
Set up for
Success
At Trinity University, we offer hands-on learning opportunities and career and academic support for our students from their first day on campus. The result? Our Tigers are all-around leaders, graduating with the tools to lead a conversation, lead a community, and lead lasting change.
Meet two recent alumnae who are set up for success.
Sena Saygili ’23
Learn how this neuroscience major overcame all odds and followed her heart to medical school.


Carol Balaguer ’24
Learn how this accounting major’s experiences abroad, in the classroom, and in her career field have made her feel secure about her future.
The Trinity University Journey Video Series
Hear from Sena, Carol, and other Tigers who are set up for success.
9
Trinity University Creates Leaders, TIME Says
Trinity named among top schools in nation for developing leadership
By Jeremy Gerlach
TIME Magazine, in partnership with data-gathering platform Statista, has released a new ranking for the Best Colleges for Future Leaders, with Trinity University checking in at No. 62. This list includes Ivy Leagues, large research universities, and other household names that have significant research and graduate programs. Trinity stands out as one of only six liberal arts schools on the list.
This TIME ranking comes after our Niche ranking as the No. 19 liberal arts college in the nation and U.S. News and World Report ranking as the No. 19 most innovative school in the nation.
Trinity’s success on these lists is no secret: the University’s enduring values and commitment to student success and well-being continue to spur us forward.
Trinity pairs the resources of a larger school with a small-school environment that fosters hands-on opportunities and faculty attention, strong community connections, and a tight-knit alumni network. Our Tigers answer questions and question answers in real-world


Hear From a Tiger
Meet Danny Nguyen ’24, a marketing and communication double major who values how Trinity’s experiential learning opportunities prepared him to be an allaround leader, not just an employee.
10

Explore and Experience
Our Campus and Our City
Plan a family trip to San Antonio—there’s so much to see and do! Have some fun at Six Flags Fiesta Texas or SeaWorld. Then check out downtown’s colorful River Walk and the locally owned shops and restaurants at The Pearl, former brewery turned trendy destination, both of which are just a short drive away from Trinity’s campus. We can’t wait to show you around!

Trinity In Focus Open House
Tour campus, hear from current students, chat with faculty, and learn about admissions and financial aid.
8:30 a.m.-12:30 p.m.
Saturday, June 29, 2024
Saturday, September 21, 2024 Saturday, November 9, 2024
Information Sessions and Campus Tours
Trinity’s student-led campus tours and sessions with an admissions representative are available most weekdays year round, as well as select Saturdays in the fall and spring.
Summer Schedule
Monday-Friday (except University holidays) 9:20-11:15 a.m.
Interested in Becoming a Tiger?
Apply Early!
Applications open for first-year students applying for the Class of 2029 on August 1, 2024, via the Common Application, the Coalition Application powered by SCOIR, and ApplyTexas.
Know Early!
Is Trinity your top choice? Apply via Early Decision (ED) I to lock in your admissions decision and scholarship eligibility by December 1.* As you explore Trinity, we encourage you to start reviewing the benefits and myths about applying ED at gotu.us/ earlydecision. You can even request an early financial aid estimate!
*This program is a binding agreement. Students are ethically bound to apply ED to only one school and will be expected to attend if offered admission.
Join Us for Summer Interviews
Attention rising seniors: Don’t miss your chance to stand out in the admissions process!
This summer, we encourage you to meet one-on-one with a representative of Trinity University, either in your hometown or virtually. Students should interview before their intended application deadline. Fall interviews will be very limited, so schedule your interview today! To view interview dates and register, visit gotu.us/interviews.
Explore all visit options at gotu.us/visit 11

QUICK FACTS


2,581 undergraduates from 45 states and 41 countries
ADMITTED STUDENT PROFILE Fall 2023 Entry Term
3.81 mean GPA core, unweighted 4.0 scale
30-34 mid 50% ACT mean: 32
1350-1480 mid 50% SAT mean: 1413
11,425 applications 28% admit rate
Follow us on social media! minutes from downtown San Antonio 6 acre campus located in a residential neighborhood 125 student-to-faculty ratio 97% of faculty hold doctoral or terminal degrees
www.trinity.edu @trinityu and @trinityuadmissions @trinityuniversity /trinityuniversity Private, undergraduate-focused, residential, co-educational Founded in 1869 6 minutes from San Antonio International Airport Located in America’s 7th largest city @Trinity_U and @TrinityU_Admiss
9:1